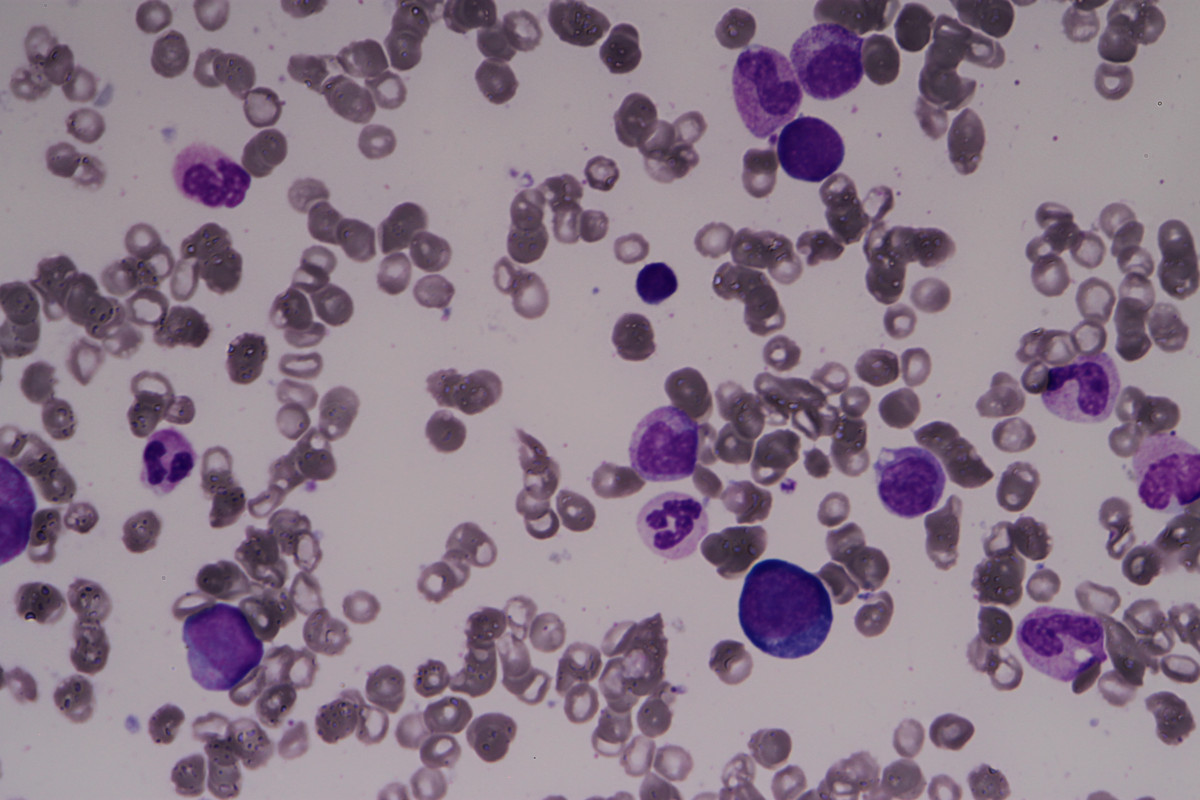

Prosím o konzultáciu k prípadu 28ročného pacienta s anamnézou opakovaných infekcií vyžadujúcich liečbu ATB (na prelome rokov 2023/2024). Pac. od 04/2024 s ťažkou anémiou NN (Hgb 63 g/L) s retikulopéniou (Ab ret. 5 x10 9 /L) a lymfopéniou (Ab Ly 0,4 x10 9 /L). Vylúčená sekundárna príčina (B12, železo, infekčná serológia vrátane parvovírusu B19, PNH, EPO vysoké). Vstupná dg. z morfológie kostnej drene obraz MDN (akcelerovaná erytropoéza, ťažká dysplázia), avšak genetika vrátane NGS, ako aj prietoková cytometria bez klonality, histológia KD útlm erytropoézy,bez dysplázie. Pac .ťažko transfúzne závislý - 4 TU ERM/mesiac(Hgb vždy pod 80 g/L), nutná chelačná liečba. Následné vyšetrenia KD (11/24, 04/25)- morfologicky už len zbytková erytropoéza (1,5%) nenájdené žiadne zrelšie formy Ery-poézy- maturačný blok na úrovni proErytro a Bazo. Dysplastické zmeny vo všetkých troch líniách, zmnožené blasty do 8%. FCM KD, genetika vrátane NGS a LPO negatívna, histológia z 04/25 aktivácia megakaryocytov, myeloblasty menej ako 5 %, výrazná eozinofília, znížená erytropoéza, mierna difúzna fibróza, malé zhluky naukladaných obrovských buniek s výraznou penovou cytoplazmou a zreteľným jadrom, vykazujúce fenotyp CD68 čiastočne+, CD163+, E-kadherín+, CD1a-, CMV-, AE1/AE3-, CD30-, CD45. Bez známok MDN/MPN. PET/CT 12/24 vyšetrenie: nuchálne bilaterálne lymfatické uzliny, so SUVmax 3,26 – reaktívne?, inak žiadne známky iného malígneho alebo zápalového procesu.
Vzhľadom na vek a ťažkú závislosť od transfúzie sme pri dg. MDN uvažovali aj o alogénnej transplantácii kmeňových buniek. Pacient však tento návrh odmietol. Vylúčili sme systémové alebo reumatické ochorenie, rovnako tiež m.Gaucher. Pacienta sme dva mesiace liečili kortikosteroidmi (prednizón 0,5 mg/kg pacienta) bez účinku. Aktuálne pretrváva ťažká anémia s retikulopéniou, intermitentne ľahká trombocytóza, lymfopénia, opakovane zvýšené LD do 9 ukt/L (normálna hodnota 4,13 ukt/L), vylúčený deficit folátu aj B12, ľahko zvýšené B2M, feritín 699 ug/ml. Vyšetrený parvovírus B19 (11/25), ktorý je t.č. PCR pozitívny, hladina timidínkinázy 463 (NH do7,5), normálne ELFO, aj Ig. Pac. bez infekčných komplikácii.
Môže sa jednať o PRCA pri chronickej infekcii parvovírus B19? Ak áno, aká by bola schéma liečby IVIG? Je nutné doplniť ešte nejaké vyšetrenia? Ďakujem za spoluprácu. V prílohe posledné vyšetrenie kostnej drene z 04/2025
Přílohy:
Reakce: 3
Dobrý den,
pokud byly poslední odběry z kostní dřeně provedeny v dubnu 2025, tak je asi čas vyšetření zopakovat (vč. odběru pa PCR na parvovirus ze dřeně). Ve své zprávě popisujete zejména červený krevní obraz a nález pravděpodobně v histologii kostní dřeně. Přes snížení erytropoézy však nepopisujete abnormální erytroblasty typické pro infekci parvovirem. Připojené obrázky se velmi špatně hodnotí, ale připadá mi, že retikulární buňky nesou známky erytrofagocytózy. Při sugestivních popisech těžké dysplasie je opravdu potřeba myslet v první řadě na MDS i když s normálním nálezem v cytogenetice a NGS. Pacient asi nemá organomeglii, že? Konečně, je pacient HIV negativní? Recidivující infekce, lymfopenie a parvovirová infekce u mladého muže....

Osobně se domnívám, že PRCA může být přítomna, ale sama o sobě nevyvolá dyplasii ve všech řadách a nárůst blastů. Jistě je třeba odběry za dřeně včetně virologie parvoviru B19 a trepanobiopsii zopakovat. Jaký je názor patologů na atypické buňky ve dřeni ? Byly při minulém vyšetření nalezeny ve dřeni gigantické proerytroblasty, jež jsou typické pro PRCA ?
Normální cytogenetika a NGS vůbec dg. MDS nevylučuje, je možno zkusit léčbu PRCA vysokými dávkami IgG (0.5g/kg) 4-5 dní, ale pokud je přítomen MDS, většinou tato léčba nestačí a metodou volby je SCT.
Čermák

Vyjádření lékaře k doporučení kolegia
Dobrý deň, posielam doplňujúce informácie: vstupná infekčná serológia: HIV, HCV, HBsAg, parvovírus B19, CMV negatívna, stav po prekonaní EBV v minulosti. Vstupne hladina EPO >750 IU/L. Pac. od mája 2024 bez akejkoľvek infekčnej komplikácie.
Atypické bunky boli patológom popísané len pri poslednom histologickom vyšetrení kostnej drene, vyjadril sa k nim neurčito- "čas ukáže". V morfológii boli popísané aj gigantické formy proerytroblastov, predpokladali sme, že ide o prejav dysplázie.
V spodnej časti detailné závery vyšetrení kostnej drene, diskrepancia medzi histológiou a morfológiou (nedalo sa to poslať osobitne ako príloha):
Histológia KD 11/2024: Reprezentatívna rebioptická vzorka spongiózy s obrazom ľahko hypocelulárnej KD pre fokálne, najmä paratrabekulárne zmnoženie tukovej drene s pretrvávajúcim parciálnym narušením kvantitatívnych aj kvalitatívnych pomerov. Granulopoéza je paratrabekulárne redukovaná, vysunutá do interstícia, kde (v kontraste k uvedeného cytologickému nálezu 10% blastov) vyzrieva bez zmnoženia blastov (CHAE+, MPO+, CD34/ CD117 ojedinele+ v menej ako 5% buniek) a so zvýšením podielu eozinofilovej komponenty. Erytropoéza je výrazne redukovaná, zväčša rozptýlená, alebo nakopená v drobných intersticiálnych zhlukoch s výraznými črtami dyserytropoézy (glykoforín A+) s prímesou ojedinelých prstencových sideroblastov pri mierne zvýšených zásobách Fe pigmentu. Mgk rad je výrazne zmnožený s náznakmi tvorby riedkych zhlukov, zastúpený pestrými formami s hyper- aj hypolobulizovanými, občas denznými jadrami a črtami dysmegakayropoézy (CD61+), v interstíciu sú fokálne zmnožené retikulínové vlákna bez difúznej fibrózy (MF0-1) a pomerne výrazná stromálna T-lymfocytóza, vrátane niekoľkých agregátov (CD3+) s prímesou početných disperzných B-buniek (CD20+, PAX-5+) bez účasti HRS buniek (PAX-5-, CD30-, IMP3/KOC1-), dôkaz CD1a je negatívny
Z á v e r : KD s dominujúcim útlmom erytropoézy nejasnej genézy a s ďaľšími opísanými zmenami hemopoézy, ktoré sú v zásade identické ako v prvej biopsii, a preto sú aj v kontexte negatívneho výsledku mol.-gen. analýzy ťažko klasifikovateľné, bez možnosti potvrdenia zvažovaného MDS. Odoprúčame pátrať po prejavoch LPO a vylúčiť imunopatologické ochorenie.
Histológia KD 04/2025: Reprezentatívna vzorka spongiózy s obrazom normocelulárnej KD pri aktivácii mgk a menej aj bieleho radu. Granulopoéza vyzrieva (CHAE+, MPO+, CD68-) so zvýraznenou eozinofíliou a s prítomnosťou menej zrelých CD117+/CD34+ prekurzorov, v rozsahu 5% buniek KD. Erytropoéza (glykoforínA+, E-cadherín+) je redukovaná, tvorí iba drobné intertrabekulárne zhluky, sčasti je rozptýlená a miestami paratrabekulárne dislokovaná, je tvorená zmesou normoblastov, makrocytov a v.s. aj megaloblastov pri mierne zvýšených zásobách Fe pigmentu. V interstíciu je takmer difúzna fibróza ľahkého stupňa (MF1). Mgk (CD61+) sú rozptýlené, miestami s tendenciou k tvorbe riedkych zhlukov, cytomorfologicky ide o pestrejšie formy tvorené stredne veľkými a menšími až malými elementami, často s hypolobulizovaným/ nelobulizovanými denznými dysmorfnými („MDS-like“) jadrami, ale sporadicky možno identifikovať aj stredne veľké formy s jemne hyperlobulizovanými jadrami. V tomto teréne nachádzame ďalej v interstíciu prevažne rozptýlené iba ojedinele v drobných zhlukoch nakopené obrovské bunky s naznačenou penovitou cytoplazmou a so zreteľným jadierkom, ktoré vykazujú fenotyp CD68 sčasti+, CD163+, E-cadherín+, CD1a-, CMV-, AE1/AE3-, CD30-, CD45-.
Záver: KD s opísanými atypiami červeného a mgk radu, ktoré v kontexte klinických údajov (a vzhľadom na veku pacienta), hodnotíme rezervovane v zmysle myeloidnej neoplázie typu MDS, pričom opísaná v.s. histiocytárna populácia má nejasný biologický význam (tezaurizmóza?, iné?). Odporúčame príslušné klinicko-laboratórne a mol.-genetické analýzy a dľa možnosti rebiopsiu s časovým odstupom.
Morfológia KD 07/2024:
Megakaryocyty prítomné+malé formy+hypolobulizované formy,na periférii náterov aj malé zhluky Mk,agregáty PLT.
Diff.na 500 jadr.bb.,prítomné zhluky nediff.hemopoet.bb.+stromálne bb.,v náteroch 57,8 % prevaha výrazne dysplastickej, makrocytovej,čiastočne až megaloblastovej erytropoézy s posunom k mladším vývojovým formám,prít.dysplastická Gr-poéza- asynchrónia vyzrievania+ parciálne prítomná hypogranulácia až agranulácia,veľa porušených bb.+holých jadier.
Sideroblasty v kostnej dreni : Negatívne 39 % Pozitívne 57 % Intermediálne 4 % Prstencové 0 %
SBL: Vo vločkách +MFS Fe prítomné,značná časť nájdená extrakorpuskulárne.
Záver: susp. MDS LB
Morfológia KD 11/2024:
Megakaryocyty prítomné,ojed. holé jadrá+ojed. menšie agregáty Tr.
Dif. na 500 jadr.bb., prítomné zhluky nedif. hemopoet. bb. Znížená granulácia-hypogranulácia Gr-poézy,asynchr. vyzrievania., posun doľava, blasty 10%. Zostatková Ery-poéza(1,2%) je makro až megaloblastoidná.
Záver: MDS IB1-2?, počkať na výsledok TB a genetiky
Morfológia KD 04/2025:
Megakarocyty prítomné, prevažne vytlačené na perifériu náterov,nájdené aj dysplastické formy, početné agregáty PLT. Diff.na 400 jadr.bb.,prít.zhluky nediff.hemopoet.bb.,v náteroch prítomná 1,5 % makrocytová,dysplastická Ery-poéza,nenájdené žiadne zrelšie formy Ery-poézy- maturačný blok na úrovni proErytro a Bazo. ??, prítomné megaloblastoidné formy. Nájdený aj väčší počet holých jadier,ktoré patria mladým vývojovým formám Ery-poézy. V myelopoéze blasty 8% . Nájdené aj dva väčšie zhluky osteoblastov.
Záver: pretrváva útlm erytropoézy s dysplastickou krvotvorbou a zmnožením blastov.
Další případy
Erytrocytóza a leukocytóza u mladého muže
Dobrý den, prosím o radu u 49 letého pacienta. Registrovaný do naší ordinace VPL od 02/2026, kdy ve vstupních odběrech leukocyty 10,4 10^9/l, erytrocyty 5,95 10^12, RDW 19 % HGB 128 g/L, MCV 71,1 fL , MCH 21,5 pg MCHC 303 g/L, v diferenciálu mírná ne...
Leukopenie
Dobrý den, prosím o radu, zda je nutné dovyšetřování leukopenie 3,3x10-9/L s neutropenií 1,7x10-9/L u jinak zdravé pacientky 48 let. Anamnesticky pouze nikotinismus 2cig/denně. Není nemocná či unavená. Dle dokumentace chronický nález. Nikdy však na h...
Leukopenie u mladé pacientky
Dobrý den, u mladé pacientky r. 2002 byla v rámci vstupních odběru u prevence zachycena leukopenie - leukocyty 1,5 10*9/l,neutrofily - abs. počet 0,58, nalezeny ovalocyty. Erytrocyty a trombocyty jsou v normě. Již min. rok byla na hematologii vyšetře...

Dobrý den, není mně jen jasný ten údaj blasty do 8 %, pak je hned v další větě blasty pod 5% (jedno je morfologie a druhé histologie??). Vzhledem k tomu že jsou popisovány jasné trilin dysplasie je údaj o počtu MB hodně důležitý protože pak bz nejspíše šlo o MDS s ev sek PRCA a od toho by ale ale odrážela i terapie. Moc prosím toto ještě ozřejmit. Protože bud bude pokračovat terapie jako u PRCA s výběrem další imunosuprese nebo bude nutné začít léčit MDS s vyšším rizikem a nejspíše nemocného nakonec s ohledem k věku přemluvit k allo translpantaci
Ještě jaká je hladina endogenního EPO?
Doc. MUDr. Anna Jonášová, PhD